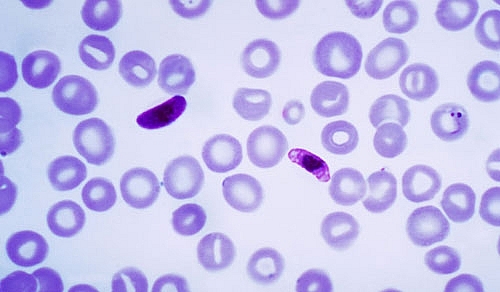
cac thuoc dieu tri benh sot ret

Bệnh sốt rét thường xảy ra ở các nước nhiệt đới và cận nhiệt đới, gây ra những tác hại nghiêm trọng về mặt sức khỏe đối với những người dân bản địa hay du khách và thậm chí còn đe dọa đến tính mạng. Tổ chức Y tế Thế giới (WHO) cho biết: năm 2016 có khoảng 216 triệu ca sốt rét ở 91 quốc gia, với số lượng tử vong lên đến 445.000 người.
Tìm hiểu về bệnh sốt rét
Bệnh sốt rét (Malaria) do các ký sinh trùng sốt rét Plasmodium gây ra. Muỗi cái Anopheles bị nhiễm các ký sinh trùng này chính là tác nhân trung gian lây truyền bệnh sang người.
Nguyên nhân:
Bệnh sốt rét được lây truyền từ muỗi sang người qua đường máu, khi người bị muỗi cái Anopheles nhiễm ký sinh trùng sốt rét đốt.
Ngoài ra, muỗi cái Anopheles không nhiễm bệnh khi hút máu người mang mầm bệnh sốt rét sẽ lây truyền sang người khác khi đốt. Một người mẹ bị nhiễm bệnh cũng có thể truyền bệnh cho em bé khi sinh, được gọi là bệnh sốt rét bẩm sinh.
![]() |
| Muỗi cái Anopheles, trung gian lây truyền bệnh |
Có bốn loại ký sinh trùng sốt rét Plasmodium lây bệnh sốt rét sang người:
- Plasmodium vivax.
- Plasmodium ovale.
- Plasmodium malariae.
- Plasmodium falciparum.
Trong số này, Plasmodium falciparum gây ra dạng BSR (sốt rét ác tính) nghiêm trọng nhất và có nguy cơ tử vong cao.
Các ký sinh trùng Plasmodium sinh sống ở trong máu hay gan và dần dần phá vỡ hồng cầu, khiến cơ thể người mắc bệnh sốt rét suy nhược, thiếu máu… và có thể dẫn đến tử vong.
Triệu chứng:
Bệnh sốt rét thường tái phát với các triệu chứng: Sốt cao, ớn lạnh, run, đổ mồ hôi, nhức đầu, đau nhức cơ, nôn ói, tiêu chảy…
Trong trường hợp nghiêm trọng do Plasmodium falciparum gây ra: Suy thận, suy gan, hôn mê, tử vong.
Các triệu chứng sốt rét thường bắt đầu trong vòng vài tuần sau khi bị muỗi nhiễm bệnh đốt. Tuy nhiên, một số loại ký sinh trùng sốt rét có thể tồn tại ở dạng ngủ yên, không hoạt động trong cơ thể một năm.
![]() |
Ký sinh trùng sốt rét plasmodium |
Các thuốc điều trị bệnh sốt rét
Các thuốc được sử dụng trong điều trị bệnh sốt rét tùy thuộc vào loại ký sinh trùng lây bệnh, vùng bị nhiễm bệnh và tình trạng kháng thuốc.
Nhóm alkaloid của cây canh ki na (Cinchona Sp. Rubiaceae): quinin, quinidin… có tác dụng diệt thể phân liệt và giao bào trong hồng cầu, thường được sử dụng qua đường tĩnh mạch, trong điều trị bệnh sốt rét do p.falciparum gây ra ở các vùng đa kháng thuốc.
Nhóm dẫn chất 4 aminoquinolin: cloroquin, hydroxycloroquin… được sử dụng trong phòng ngừa và điều trị bệnh sốt rét, có tác dụng diệt thể phân liệt trong hồng cầu của các loại ký sinh trùng sốt rét.
Nhóm dẫn chất 8 aminoquinolin: primaquin, tafenoquin… được sử dụng trong phòng ngừa và điều trị bệnh sốt rét, có tác dụng diệt thể phân liệt trong gan của các loại ký sinh trùng sốt rét.
Nhóm thuốc này thường được sử dụng sau các loại thuốc khác (như cloroquin) có tác dụng tiêu diệt ký sinh trùng sốt rét sống trong hồng cầu.
Nhóm quinolin methanol: mefloquin, halofantrin, lumefantrin… được sử dụng trong phòng ngừa và điều trị bệnh sốt rét, có tác dụng diệt thể phân liệt trong máu của các loại ký sinh trùng sốt rét.
Nhóm thuốc antifolates: pyrimethamin, proguanil, sulfadoxin… có tác dụng ức chế tổng hợp axít folic, là nguyên liệu cần thiết để tổng hợp axít nuleic (AND hay ARN) cần thiết cho sự phát triển của ký sinh trùng sốt rét. Nhóm thuốc này có tác dụng diệt thể phân liệt trong máu của các loại ký sinh trùng sốt rét, nên được sử dụng trong phòng ngừa và điều trị BSR.
Nhóm thuốc kháng sinh: các thuốc kháng sinh tetracyclin, doxyclin, clindamycin có tác dụng diệt thể phân liệt của các loại ký sinh trùng sốt rét, thường được kết hợp với các loại thuốc khác trong điều trị bệnh sốt rét.
Nhóm thuốc artemisinin: artesunat, artemether, arteether… là những hoạt chất được chiết xuất từ cây Thanh hao hoa vàng (Artemisia annua L. Asteraceae). Nhóm thuốc này được sử dụng trong điều trị bệnh sốt rét, do có tác dụng diệt thể phân liệt trong máu của các loại ký sinh trùng sốt rét.
Các thuốc sử dụng trong điều trị bệnh sốt rét đều là những thuốc kê đơn, có thể gây ra các tác dụng phụ nguy hiểm, nên người bệnh tránh tự ý sử dụng và cần tuân theo đúng chỉ định của thầy thuốc.
Bên cạnh việc dùng thuốc mọi người cần tăng cường các biện pháp phòng ngừa sốt rét: Thường xuyên ngủ trong màn có tẩm hóa chất diệt muỗi; Áp dụng các biện pháp xua đuổi muỗi như: phun thuốc xịt muỗi, nhang đốt muỗi, thoa kem chống muỗi…; Vệ sinh môi trưởng để loại bỏ những nơi trú ẩn của muỗi; Nên uống thuốc phòng ngừa sốt rét khi đến vùng nhiễm bệnh.